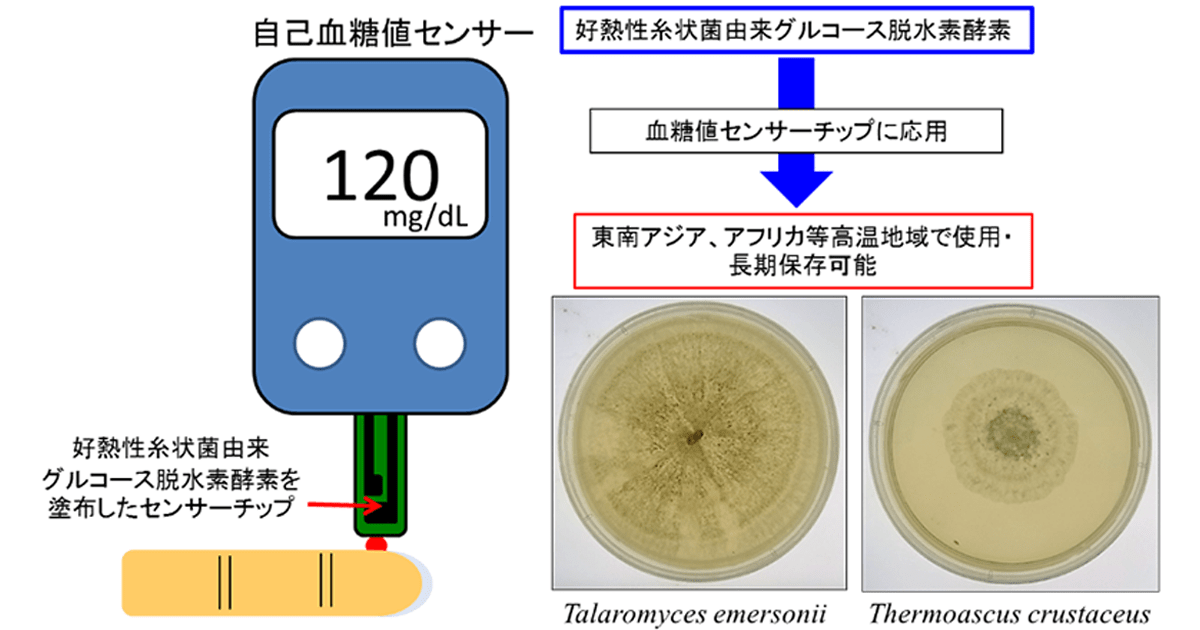
血糖値センサーチップ用の耐熱性と長期安定性に優れた酵素を発見

マイストア
変更
お店で受け取る
(送料無料)
配送する
納期目安:
2025.12.17 10:58頃のお届け予定です。
決済方法が、クレジット、代金引換の場合に限ります。その他の決済方法の場合はこちらをご確認ください。
※土・日・祝日の注文の場合や在庫状況によって、商品のお届けにお時間をいただく場合がございます。
センサー(試験紙)セット(糖尿病) 104185-13206944.webpの詳細情報
104185-13206944.webp。センサー(試験紙) | 糖尿病リソースガイド。アークレイ血糖自己測定器関連情報サイト。完全な未使用品です。。TGK - 東京硝子器械 TryWinZ / pH試験紙 高精度 CS pH1-12 11×100mm 200枚。申し訳ありませんが値下げは考えておりません。【数回使用】 オキシーズ 小型高濃度酸素発生器/ ヴィーゴ
ベストセラーランキングです
近くの売り場の商品
カスタマーレビュー
オススメ度 4.1点
現在、5851件のレビューが投稿されています。

![[動画撮影に最適] Neewern284 Amazonで星4評価 おすすめの商品](https://static.mercdn.net/item/detail/orig/photos/m42777037026_1.jpg)


